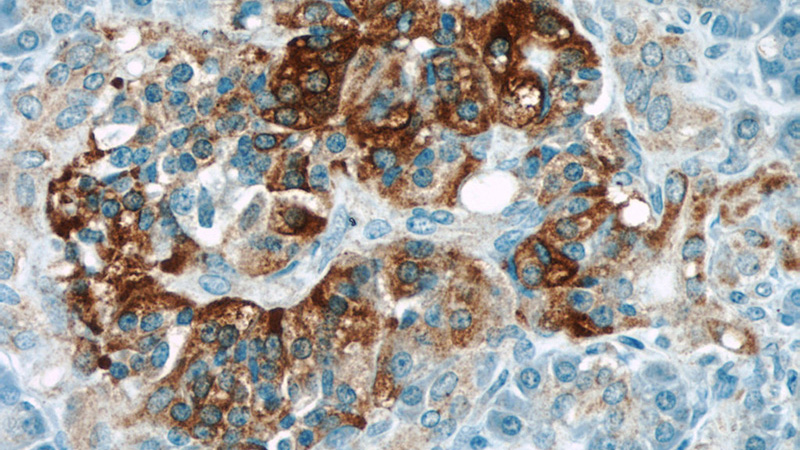
Immunohistochemical of paraffin-embedded human pancreas using Catalog No:114805(RPGRIP1L antibody) at dilution of 1:50 (under 40x lens)

-
Product Name
RPGRIP1L antibody
- Documents
-
Description
RPGRIP1L Rabbit Polyclonal antibody. Positive WB detected in HEK-293 cells, human kidney tissue. Positive IP detected in HEK-293 cells. Positive IHC detected in human pancreas tissue, human brain tissue. Observed molecular weight by Western-blot: 151 kDa
-
Tested applications
ELISA, WB, IHC, IP
-
Species reactivity
Human; other species not tested.
-
Alternative names
CORS3 antibody; DKFZp686C0668 antibody; FTM antibody; JBTS7 antibody; KIAA1005 antibody; MKS5 antibody; Protein fantom antibody; RPGRIP1 like antibody; RPGRIP1 like protein antibody; RPGRIP1L antibody
-
Isotype
Rabbit IgG
-
Preparation
This antibody was obtained by immunization of Peptide (Accession Number: NM_015272). Purification method: Antigen affinity purified.
-
Clonality
Polyclonal
-
Formulation
PBS with 0.1% sodium azide and 50% glycerol pH 7.3.
-
Storage instructions
Store at -20℃. DO NOT ALIQUOT
-
Applications
Recommended Dilution:
WB: 1:500-1:5000
IP: 1:200-1:2000
IHC: 1:20-1:200
-
Validations

HEK-293 cells were subjected to SDS PAGE followed by western blot with Catalog No:114805(RPGRIP1L antibody) at dilution of 1:800

IP Result of anti-RPGRIP1L (IP:Catalog No:114805, 4ug; Detection:Catalog No:114805 1:700) with HEK-293 cells lysate 3200ug.

Immunohistochemical of paraffin-embedded human pancreas using Catalog No:114805(RPGRIP1L antibody) at dilution of 1:50 (under 10x lens)
Immunohistochemical of paraffin-embedded human pancreas using Catalog No:114805(RPGRIP1L antibody) at dilution of 1:50 (under 40x lens)
-
Background
RPGRIP1L, also named as FTM, KIAA1005, belongs to the RPGRIP1 family. It negatively regulates signaling through the G-protein coupled thromboxane A2 receptor. RPGRIP1L may be involved in mechanisms like programmed cell death, craniofacial development, patterning of the limbs, and formation of the left-right axis.(PMID:17558409) Defects in RPGRIP1L are the cause of Joubert syndrome type 7 (JBTS7). Defects in RPGRIP1L are the cause of Meckel syndrome type 5 (MKS5). This antibody is specific to RPGRIP1L.
-
References
- Shaheen R, Shamseldin HE, Loucks CM. Mutations in CSPP1, encoding a core centrosomal protein, cause a range of ciliopathy phenotypes in humans. American journal of human genetics. 94(1):73-9. 2014.
- Roberson EC, Dowdle WE, Ozanturk A. TMEM231, mutated in orofaciodigital and Meckel syndromes, organizes the ciliary transition zone. The Journal of cell biology. 209(1):129-42. 2015.
- Lu Q, Insinna C, Ott C. Early steps in primary cilium assembly require EHD1/EHD3-dependent ciliary vesicle formation. Nature cell biology. 17(4):531. 2015.
Related Products / Services
Please note: All products are "FOR RESEARCH USE ONLY AND ARE NOT INTENDED FOR DIAGNOSTIC OR THERAPEUTIC USE"
